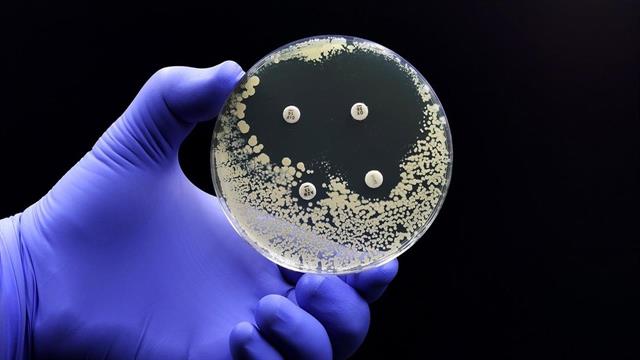
Ανακαλύφθηκαν νέα αντιβιοτικά στο έντερο υγιών ανθρώπων

Το μικροβίωμα στο ανθρώπινο έντερο είναι μια ανεξερεύνητη πηγή νέων αντιβιοτικών. Κατά τη διάρκεια μιας συστηματικής αναζήτησης, μια αμερικανική ομάδα βρήκε 78 δυνητικά αντιμικροβιακά πεπτίδια, περισσότερα από τα μισά από τα οποία ήταν σε θέση να σκοτώσουν βακτήρια σε κυτταρικές καλλιέργειες.
Σύμφωνα με τα αποτελέσματα που δημοσιεύονται στην επιθεώρηση "Cell", οι λοιμώξεις του δέρματος και των μαλακών μορίων σε ποντίκια μπορούσαν να αντιμετωπιστούν με επιτυχία.
Στο παρελθόν, η ανακάλυψη νέων αντιβιοτικών ήταν μια επίπονη προσπάθεια. Οι μικροβιολόγοι έψαχναν σε αρχέγονα δάση και βάλτους προς αναζήτηση ασυνήθιστης μούχλας, τα συστατικά της οποίας στη συνέχεια δοκιμάζονταν σε τρυβλία Petri ως προς την ικανότητά τους να σκοτώνουν βακτήρια. Τα τρυβλία Petri είναι πλαστικά, ρηχά, στρογγυλά πιάτα που χρησιμοποιούνται από τους μικροβιολόγους για την καλλιέργεια μικροοργανισμών.
Μια ομάδα με επικεφαλής τον César de la Fuente από την Ιατρική Σχολή Perelman στη Φιλαδέλφεια ξεκίνησε με μια αναζήτηση σε βάση δεδομένων στον ιστότοπο του Human Microbiome Project.
Εκεί, οι ερευνητές αναζήτησαν τα δεδομένα 1.773 μεταγονιδιωμάτων. Πρόκειται για το σύνολο όλων των αλληλουχιών γονιδίων που είχαν βρει άλλοι ερευνητές στα μικροφίλμ της στοματικής κοιλότητας, του δέρματος, του εντέρου ή του κόλπου.
Χρησιμοποιώντας λογισμικό, η ομάδα εντόπισε 2,5 εκατομμύρια "μικρά ανοικτά πλαίσια ανάγνωσης", δηλαδή τμήματα γονιδίων που μπορεί να κωδικοποιούν πρωτεΐνες.
Οι ερευνητές βρήκαν τα σχέδια 444.054 βακτηριακών πρωτεϊνών. Το λογισμικό AmPEP χρησιμοποιήθηκε για τον εντοπισμό 323 πεπτιδίων των οποίων οι αλληλουχίες ήταν παρόμοιες με γνωστά αντιμικροβιακά πεπτίδια. Από αυτά, οι ερευνητές επέλεξαν στη συνέχεια 78 υποψήφια πεπτίδια.
Οι πραγματικές πρωτεΐνες συντέθηκαν από τα 78 υποψήφια πεπτίδια, τα οποία προηγουμένως ήταν μόνο ένα αρχείο υπολογιστή με μια γονιδιακή αλληλουχία. Στη συνέχεια χρησιμοποιήθηκαν για τον εμβολιασμό 11 διαφορετικών βακτηριακών καλλιεργειών σε ένα κλασικό μικροβιολογικό πείραμα.
Σε αυτές περιλαμβάνονταν διάφορα μικρόβια Eeskape, τα οποία ο Παγκόσμιος Οργανισμός Υγείας (ΠΟΥ) θεωρεί ότι αποτελούν σήμερα τα πιο απειλητικά βακτηριακά παθογόνα. Οι ερευνητές διερεύνησαν επίσης κατά πόσον τα 78 υποψήφια πεπτίδια επιτέθηκαν σε 13 κοινά φυσιολογικά εντερικά βακτήρια.
55 από τα 78 πεπτίδια ήταν αποτελεσματικά in vitro έναντι τουλάχιστον ενός από τα παθογόνα που εξετάστηκαν. Μεταξύ αυτών περιλαμβάνονταν πέντε πεπτίδια που σκότωναν επίσης το Acinetobacter baumannii, ένα φοβερό νοσοκομειακό παθογόνο που προκαλεί, μεταξύ άλλων, λοιμώξεις μαλακών μορίων.
Τα 5 αντιβιοτικά δοκιμάστηκαν στη συνέχεια σε ποντίκια στα οποία οι ερευνητές είχαν δημιουργήσει αποστήματα και βαθιές λοιμώξεις μαλακών μορίων. Ένα από τα 5 αντιβιοτικά, το Prevotellin-2 από το εντερικό βακτήριο Prevotella copri, πέτυχε αποτέλεσμα συγκρίσιμο με εκείνο του εφεδρικού αντιβιοτικού Polymyxin B.
Αυτό το καθιστά πιθανό υποψήφιο για τη θεραπεία σοβαρών λοιμώξεων. Οι ερευνητές το βρήκαν χωρίς να ταξιδέψουν σε εξωτικές χώρες και να ψάξουν για μήνες και χρόνια στη φύση για ένα αντιβιοτικό που θα μπορούσε να είναι αποτελεσματικό κατά των σοβαρών λοιμώξεων στον άνθρωπο. Βρήκαν το αντιβιοτικό στο έντερο υγιών ανθρώπων.
Αυτό δεν αποτελεί έκπληξη για τον de la Fuente. Εξάλλου, τα 100 τρισεκατομμύρια μικρόβια που αποικίζουν τις εσωτερικές ή εξωτερικές επιφάνειες του σώματος βρίσκονται σε ένα εξίσου εχθρικό περιβάλλον όπως στη ζούγκλα ή στους βάλτους.
Εκεί μπορούν να επιβιώσουν μόνο εκείνα που αμύνονται έναντι των γειτόνων τους, και τα αντιμικροβιακά πεπτίδια είναι ένα αποτελεσματικό μέσο για να το κάνουν αυτό, γράφει ο ειδικός.
Πηγές:
Cell
Ειδήσεις υγείας σήμερα
Ημέρα του Πατέρα: Διατροφικές επιλογές για καλύτερη υγεία
Πρωινές συνήθειες που βοηθούν στη δυσκοιλιότητα
Βρώμη και κινόα: Πώς συγκρίνονται από άποψη πρωτεΐνης
Πιο αποτελεσματική η αντιμετώπιση των ανθεκτικών μικροβίων με τη σωστή σειρά των αντιβιοτικών
Πιο αποτελεσματική η αντιμετώπιση των ανθεκτικών μικροβίων με τη σωστή σειρά των αντιβιοτικών Μικροβιακή αντοχή: Μία πανδημία σε αργή κίνηση που μπορούμε να αποτρέψουμε
Μικροβιακή αντοχή: Μία πανδημία σε αργή κίνηση που μπορούμε να αποτρέψουμε Οι μεγαλύτεροι ''μαγνήτες'' μικροβίων
Οι μεγαλύτεροι ''μαγνήτες'' μικροβίων Η ΕΕ επενδύει 30 εκατομμύρια ευρώ για την καταπολέμηση της μικροβιακής αντοχής
Η ΕΕ επενδύει 30 εκατομμύρια ευρώ για την καταπολέμηση της μικροβιακής αντοχής Μικρόβια σε όγκους επηρεάζουν την αποτελεσματικότητα των θεραπειών
Μικρόβια σε όγκους επηρεάζουν την αποτελεσματικότητα των θεραπειών Τεστ ανάλυσης μικροβιώματος: Πού, πώς και γιατί να το κάνω
Τεστ ανάλυσης μικροβιώματος: Πού, πώς και γιατί να το κάνω Ημέρα του Πατέρα: Διατροφικές επιλογές για καλύτερη υγεία
Ημέρα του Πατέρα: Διατροφικές επιλογές για καλύτερη υγεία Πρωινές συνήθειες που βοηθούν στη δυσκοιλιότητα
Πρωινές συνήθειες που βοηθούν στη δυσκοιλιότητα Βρώμη και κινόα: Πώς συγκρίνονται από άποψη πρωτεΐνης
Βρώμη και κινόα: Πώς συγκρίνονται από άποψη πρωτεΐνης Απ. Παπαλάκης: Ραγδαία αύξηση περιστατικών καρκίνου της ουροδόχου κύστης
Απ. Παπαλάκης: Ραγδαία αύξηση περιστατικών καρκίνου της ουροδόχου κύστης Ρύζι, πατάτες και ζυμαρικά: Ποιο είναι χειρότερο για το σάκχαρο;
Ρύζι, πατάτες και ζυμαρικά: Ποιο είναι χειρότερο για το σάκχαρο; Με ποιες τροφές να συνδυάζω ρύζι, πατάτες και ζυμαρικά για να μην αυξάνεται απότομα το σάκχαρο
Με ποιες τροφές να συνδυάζω ρύζι, πατάτες και ζυμαρικά για να μην αυξάνεται απότομα το σάκχαρο Pharmathen: Βαθιά κρίση και μηδενισμός αποτίμησης από funds της Partners
Pharmathen: Βαθιά κρίση και μηδενισμός αποτίμησης από funds της Partners Καρπούζι: Ποια είναι τα οφέλη του στην υγεία
Καρπούζι: Ποια είναι τα οφέλη του στην υγεία Ισχυρή πρωτιά της ΔΗΚΙ στις εκλογές του Ιατρικού Συλλόγου Αθηνών - Ρεκόρ συμμετοχής
Ισχυρή πρωτιά της ΔΗΚΙ στις εκλογές του Ιατρικού Συλλόγου Αθηνών - Ρεκόρ συμμετοχής Ιατρικός Σύλλογος Θεσσαλονίκης: Σαρωτική επικράτηση της ΕΝΟ.ΣΥ. - Ν.Ι.Κ.Ι.
Ιατρικός Σύλλογος Θεσσαλονίκης: Σαρωτική επικράτηση της ΕΝΟ.ΣΥ. - Ν.Ι.Κ.Ι. Φαρμακοβιομηχανίες σκέφτονται να χτυπήσουν την πόρτα της Εθνικής Αρχής Διαφάνειας
Φαρμακοβιομηχανίες σκέφτονται να χτυπήσουν την πόρτα της Εθνικής Αρχής Διαφάνειας Οι απρόσμενες συνέπειες της ολοκληρωτικής παράλειψης της ζάχαρης από τη διατροφή [μελέτη]
Οι απρόσμενες συνέπειες της ολοκληρωτικής παράλειψης της ζάχαρης από τη διατροφή [μελέτη]